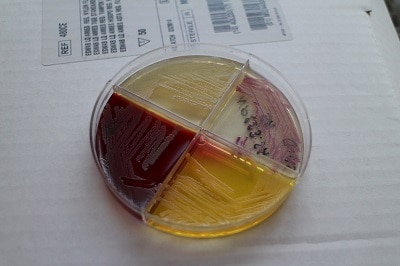

Antibiotic Resistance is a serious and growing phenomenon in contemporary medicine and has emerged as one of the pre-eminent public health concerns of the 21st century.
In countries like India, where antibiotics can be bought easily without a prescription, the emergence and spread of resistance have become severe.
As the world discusses this growing challenge during the World Antibiotic Awareness Week (November 18 to 24), here are some of our findings on the reasons behind this phenomenon and how this challenge can be addressed.
Antibiotic Resistance: Factsheet
What is antibiotic resistance (ABR) and why is ABR a global concern?
World Antibiotic Awareness Week – Social Media Material
Download and share this material on social media to help us raise global awareness of antibiotic resistance.
Antibiotic Resistance: Drug-resistant infections are a looming challenge around the world
Until 2017, MSF worked on antibiotic resistance in collaboration with the Ministry of Health in Asansol, West Bengal, India.
Antibiotic Resistance: Broader Implications for Humanity
Dr. Sakib Burza, Medical Advisor, MSF Asia explains the different drivers of antibiotic resistance and what can be done to address this hidden public health challenge.
Antibiotics: Handle with care
Antibiotics are often over-prescribed by medical practitioners and over-used by the people. But is it all dark days ahead? MSF doctor Alan De Lima Pereira breaks the issue down and tells us what we need to do.



